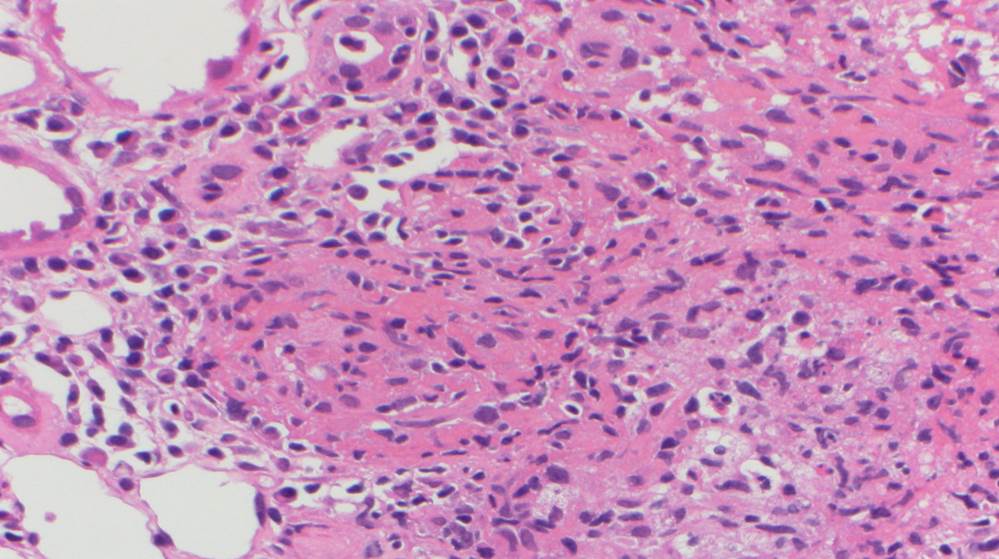

Case history:
A 33 year-old female with ESRD 2/2 DM and simultaneous renal and pancreas transplant 4 years ago. Now with fever, hematuria, diarrhea and bloating. Noted to have a creatinine of 6.7 (baseline 1.1). Renal biopsy.
What is the diagnosis:
- Acute cellular rejection
- Acute humoral rejection
- Polyoma virus nephropathy
- Adenovirus nephritis
Answer:
The answer is “D,” Adenovirus nephritis.


Discussion:
Human adenovirus is a linear, non-enveloped, double-stranded DNA virus that typically causes mild respiratory, gastrointestinal, and conjunctival illnesses in healthy persons. In kidney transplant recipients, urinary tract infection is the most frequently reported manifestation. The most frequent signs and symptoms at presentation include dysuria, fever, hematuria, sterile pyuria and acute kidney injury.
A renal allograft biopsy is essential to differentiate adenoviral nephritis from that of acute rejection or other pathology. Typical light microscopic findings in adenovirus nephropathy include tubular cell necrosis (with tubular basement membrane rupture) associated with severe interstitial inflammation (sometimes with granuloma formation), focal interstitial hemorrhage and viral cytopathic changes including peripheral condensed chromatin, basophilic nuclear inclusions and nuclear enlargement. In some cases such as ours, viral inclusions are not identified, presumably because of the focal nature of viral infection in the kidney. Immunoperoxidase staining can be used to confirm the presence of adenovirus within the nuclei, and to a lesser degree, within the cytoplasm of tubular epithelial cells; although weak, our case showed positive staining. These viral particles are visible under electron microscopy, measuring approximately 75 nm, however they were absent in our patient. Diagnosis in such cases can be clinched by urine examination showing white cell casts and decoy cells, and PCR on the urine testing positive for viral DNA.
Symptomatic patients with human adenovirus viremia and two or more organ systems involved is considered disseminated disease. There is limited literature on the optimal treatment of adenovirus nephritis. Furthermore, the role of antiviral therapy remains uncertain, with no particular therapy having proven clinical effect against this virus. There are data to support the use of ribavirin, cidofovir and immunoglobulin preparations, particularly in patients with hypogammaglobulinaemia who are at increased risk of severe opportunistic infections.
References
Jennette J, Olson J, Silva F, D’Agati V. Hepinstall’s Pathology of the Kidney. 7th ed. Philadelphia, PA: Wolters Kluwer, 2015. 1403-1413.
Hatlen T, Mroch H, Tuttle K, et al. Disseminated Adenovirus Nephritis After Kidney Transplantation. Kidney International Reports. 2018;3(1):19-23. doi:10.1016/j.ekir.2017.08.004.
Rady K, Walters G, Brown M, Talaulikar G. Allograft adenovirus nephritis. Clinical Kidney Journal. 2014;7(3):289-292. doi:10.1093/ckj/sfu020.
Case contributed by Frida Rosenblum M.D., Assistant Professor, Laboratory Medicine, UAB Department of Pathology